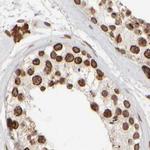
NIPA Antibody in Immunohistochemistry (IHC)

Search
Invitrogen
NIPA Polyclonal Antibody
{{$productOrderCtrl.translations['antibody.pdp.commerceCard.promotion.promotions']}}
{{$productOrderCtrl.translations['antibody.pdp.commerceCard.promotion.viewpromo']}}
{{$productOrderCtrl.translations['antibody.pdp.commerceCard.promotion.promocode']}}: {{promo.promoCode}} {{promo.promoTitle}} {{promo.promoDescription}}. {{$productOrderCtrl.translations['antibody.pdp.commerceCard.promotion.learnmore']}}
产品信息
PA5-54954
种属反应
宿主/亚型
分类
类型
抗原
偶联物
形式
浓度
规格
纯化类型
保存液
内含物
保存条件
运输条件
RRID
产品详细信息
Immunogen sequence: IQVHVTACIL SVCGWACSSS LESMQLSLIT CSQCMRKVGL WGFQQIESSM TDLDASFGLT SSPIPGLEGR PERLPLVPES PRRMMTRSQD
Highest antigen sequence identity to the following orthologs: Mouse - 86%, Rat - 86%.
靶标信息
This gene encodes an F-box-containing protein that is a component of an SCF-type E3 ubiquitin ligase complex that regulates the onset of cell division. The G2/M transition in the cell cycle requires the interaction of the proteins cyclin B1 and cyclin-dependent kinase 1. The activated ubiquitin ligase complex targets the protein cyclin B1 for degradation, preventing this transition to mitosis.
仅用于科研。不用于诊断过程。未经明确授权不得转售。
篇参考文献 (0)
生物信息学
蛋白别名: C3HC type 1; hematopoietic stem/progenitor cell protein 216; hNIPA; mNIPA; nuclear interacting partner of ALK; nuclear interacting partner of anaplastic lymphoma kinase (ALK); Nuclear-interacting partner of ALK; Nuclear-interacting partner of anaplastic lymphoma kinase; OTTHUMP00000212330; unnamed protein product; Zinc finger C3HC-type protein 1; zinc finger, C3HC-type 1
基因别名: 1110054L24Rik; AU018540; AU019789; HSPC216; NIPA; RGD1561099; ZC3HC1
UniProt ID: (Human) Q86WB0, (Mouse) Q80YV2
Entrez Gene ID: (Human) 51530, (Rat) 296957, (Mouse) 232679